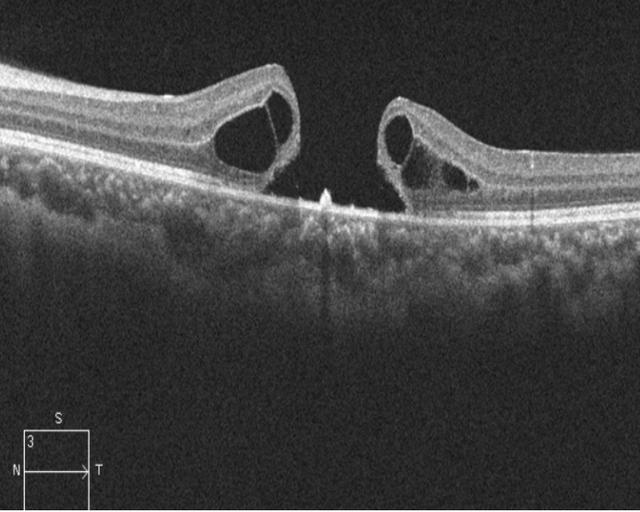
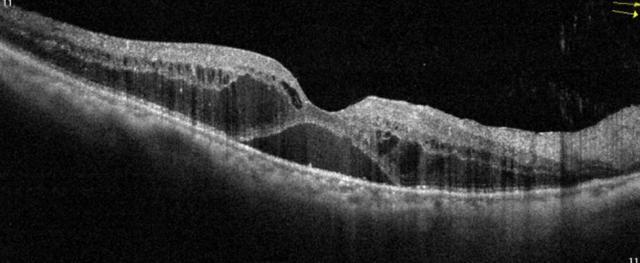
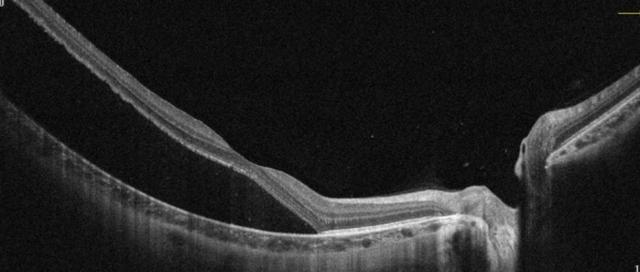

#长沙头条##长沙爱尔眼科#
在医院看眼病,医生建议做眼OCT检查时,不少人满脸疑惑:只听说CT检查,这OCT到底是啥?
眼OCT的全名叫光学相干断层扫描,是前沿的影像学诊断“神器”。原理基于光学干涉,向检测部位发射特殊光束,再捕捉反射光形成高分辨率图像,精准度达微米级,能够给视网膜一个“超清特写”,细微异常都能显现。
在眼科,它是“护眼神助攻”。视网膜病变常隐匿,传统检查难察觉,OCT却能分层剖析视网膜,黄斑水肿、视网膜裂孔等问题瞬间“现形”,助眼科医生直击病灶,把握治疗先机,守护视力。
眼底OCT检查能检测多种眼部疾病,主要包括以下几类:
一、黄斑部疾病
1、黄斑裂孔:OCT检查可以清晰地显示黄斑区视网膜神经上皮层的断裂,明确裂孔的大小、形态和深度,帮助医生判断病情的严重程度。例如,特发性黄斑裂孔在OCT图像上呈现为黄斑中心凹处的视网膜组织缺损。
(图为黄斑裂孔)
2、黄斑水肿:当黄斑区出现水肿时,OCT能够测量视网膜各层厚度的变化,精准定位水肿的位置和范围。像糖尿病性黄斑水肿,OCT图像中可见黄斑区视网膜增厚,层间出现液性暗区。
对黄斑疾病来说,黄斑裂孔术后,OCT能精准呈现裂孔愈合情况。刚做完手术,它可观察视网膜神经上皮层贴合度;后续随访中,查看有无新的积液、裂孔复发迹象,细微到微米级的变化都逃不过 OCT“法眼”。
黄斑水肿经药物、激光治疗后,用OCT监测视网膜厚度,若厚度渐趋正常,意味着水肿在消退;反之,能及时提示眼科医生调整用药及治疗方案。
(图为糖尿病黄斑水肿)
二、视网膜疾病
1、视网膜脱离:通过OCT检查能清楚看到视网膜神经上皮层与色素上皮层之间的分离情况,辅助医生确定治疗方案。
(图为视网膜脱离)
2、视网膜血管疾病:如视网膜静脉阻塞,OCT可以显示视网膜各层结构的改变以及视网膜内有无新生血管形成等。
视网膜脱离复位手术后,OCT扫描宛如“复查标尺”。清晰展现视网膜各层复位状态,有无层间积液、视网膜再次脱离风险,让医生依据图像精准判断预后,患者也能心中有数。
三、青光眼的诊断
OCT能够清晰地呈现视网膜神经纤维层(RNFL)的细微结构,其分辨率可达到微米级,可清楚地显示RNFL的厚度变化,而青光眼早期主要损害的就是RNFL,OCT有助于青光眼的早期发现。
例如,正常的RNFL在OCT图像中是完整均匀的,而青光眼患者的RNFL在图像上会出现某一象限变薄甚至缺损的区域。
OCT可以精确测量出RNFL的厚度数值,同时还能对黄斑区视网膜神经节细胞复合体进行量化分析。
对于医生而言,这不仅有利于青光眼的精准诊断,还有助于长期跟踪患者病情的进展情况,评估治疗效果。对于患者而言,长期用药或手术后,RNFL厚度是病情晴雨表,若厚度稳定,说明眼压控制得当;变薄则警示眼压失控、病情进展。
(OCT对视网膜神经纤维层及节细胞GCL厚度分析)
长沙爱尔眼科医院提醒:眼部患病后,治疗并非一劳永逸,定期随访至关重要,而OCT检查就是其中的关键一环。得益于无创、不接触眼球、高分辨率优势,OCT检查高效又舒适,可以多次重复进行,不仅为患者复查减负,也为医生动态监测患者病情、合理调整治疗方式提供有利依据,为更好地守护患者健康增添保障!
湖南医聊特约作者:医学影像科 周敏
关注@湖南医聊,获取更多健康科普资讯!
(编辑YT)